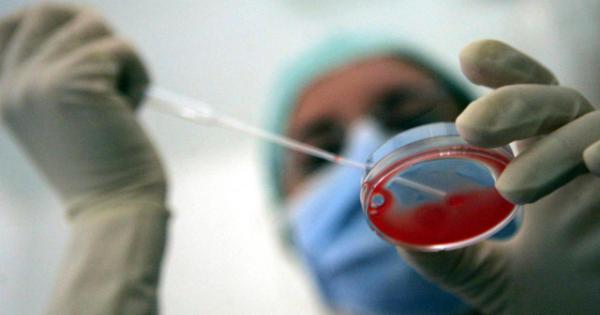
https://www.gazzettadiparma.it/resizer/600/315/true/ansa/2025_12_15/99ad7a6ebd507fe1ab196082816342fb.jpg--.jpg

Il segreto del Milan
- Postato il 13 dicembre 2025
- Di Il Foglio
- 4 Visualizzazioni

Il segreto del Milan
Quando il calcio si giocava più lentamente, c’era chi, ogni tanto, si concedeva il lusso di una pausa. Come il poetico calciatore (e poi scrittore) Ezio Vendrame, che si arrestava con il pallone so... Contenuto a pagamento - Accedi al sito per abbonarti Continua a leggere...